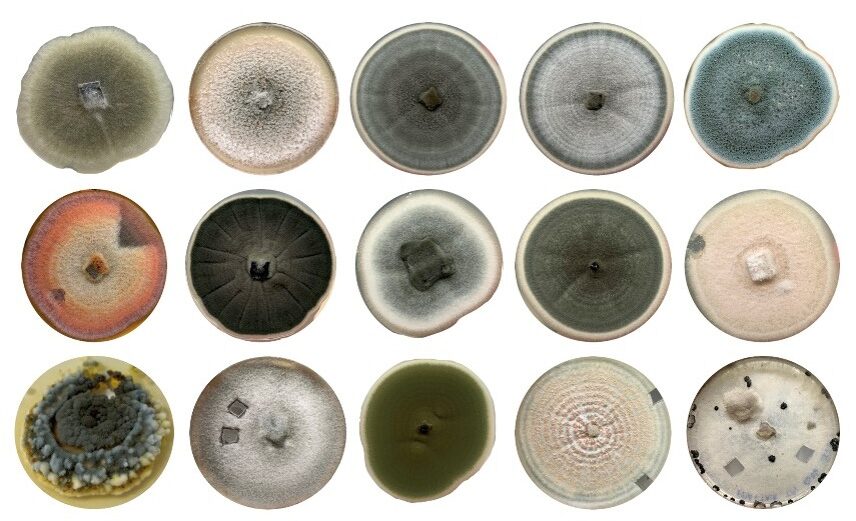

Biography
Lorena is a plant pathologist in the epidemiology group within the Cell and Molecular Sciences department. Her research focuses on the foliar microbiome of agricultural crops or their wild progenitors and how phytopathogenesis impacts community structure. In particular, she is interested in investigating the potential to exploit the foliar and endophytic microbiome for tailored disease control of plant pathogenic bacteria and fungi.
Research
Current Research Interests and Impact
Current research focuses on how native plant-associated microbiomes, particularly those of the phyllosphere or above ground tissues, can be leveraged to enhance plant health and resilience to biotic stress. Emphasis is placed on locally adapted microbial communities, including fungi, yeasts and bacteria, and their roles in disease suppression and ecosystem function. Using metabarcoding and eDNA approaches, our work profiles these microbial communities across plant systems to inform sustainable, crop-agnostic biocontrol strategies. A central aim is to catalogue microbiome diversity in the phyllosphere and endosphere (within plant tissue) to identify ecological principles underpinning plant–microbe interactions. This work is supported by a curated culture collection of fungal, yeast, and bacterial isolates that underpins both ecological research and downstream application.
This work is closely aligned with translational and commercial objectives, recognising the phyllosphere as a vast and underexplored microbial habitat with significant biotechnological potential. By linking microbial community structure to functional traits, such as secondary metabolite production and plant-beneficial activities, this work supports the discovery and development of novel products and applications. These include disease-suppressive and plant growth–promoting microbes, as well as bio-based industrial compounds and microbiome-informed surveillance tools for plant health, food safety, and biosecurity.
This work is conducted as part of a wider team of scientists at the James Hutton Institute contributing to Integrated Pest Management (IPM), supporting the key actions of the UK National Action Plan for the Sustainable Use of Pesticides. Through global collaboration and a focus on Scotland’s ambitions, this research integrates knowledge of pest and pathogen biology to reduce reliance on chemical pesticides while maintaining agricultural productivity and protecting the environment. Related work is highlighted in a group blog on research innovations driving Scotland’s transition to reduced pesticide use.
Click image to visit publication. Rangel, L.I., Leveau, J.H.J. Applied microbiology of the phyllosphere. Appl Microbiol Biotechnol 108, 211 (2024). https://doi.org/10.1007/s00253-024-13042-4
Foliar Microbiome Research
-
- Phyllosphere (epiphyte & endophtye) characterisation of healthy/diseased signatures
- Assessing function of hub taxa for crop protection
- Biocontrol of plant pathogenic bacteria and fungi
- Work with industry towards creation of safe biologicals


Secondary Metabolite Research
- Discovery of SM involvement in phytopathogenesis
- Identification of cross-kingdom SM communication
- Validating function of SM gene clusters
- Improve crop protection through alternative biopesticides
Past research
Previous Experience
2019-2023 Post-doctoral Research Plant Pathologist, USDA-ARS, Fargo, North Dakota, USA
2019 Ph.D. Plant Pathology – University of California, Davis, California, USA
2012 M.S. Plant Pathology – Oregon State University, Corvallis, Oregon, USA
2010 B.S. Microbiology minor Chemistry – Texas State University, San Marcos, Texas, USA
Publications
Rangel, L.I., Rastogi, G., Williams, T.R. and Leveau, J.H., 2025. Bacterial Auxin Production in the Phyllosphere. Phytobiomes Journal, pp.PBIOMES-02. https://doi.org/10.1094/PBIOMES-02-25-0010-R
Fredell, G., Bienkowski, D., Light, S.E. and Rangel, L.I., 2025. Distribution, potential commercial adoption, and possible impacts of the endophytic fungus, Epichloë, in UK pasture grasses and cereals. CABI Plant Health Cases. https://doi.org/10.1079/planthealthcases.2025.0002
Rangel, L.I., Wyatt, N., Courneya, I., Natwick, M.B., Secor, G.A., Rivera-Varas, V., & M.D. Bolton. 2024. CbCyp51 mediated DMI resistance is modulated by codon bias. Phytopathology. https://doi.org/10.1094/PHYTO-01-24-0034-R
Rangel, L.I. & J.H.L. Leveau. 2024. Applied microbiology of the phyllosphere. Applied Microbiology and Biotechnology. 108: 211. https://doi.org/10.1007/s00253-024-13042-4
Rangel, L.I. & M.D. Bolton. 2022. The unsung roles of microbial secondary metabolite effectors in the plant disease cacophony. Current Opinion in Plant Biology. 68: 102233. https://doi.org/10.1016/j.pbi.2022.102233
Rangel, L.I., Hamilton, O., de Jonge, R., & M.D Bolton. 2021. Fungal social influencers: secondary metabolites as a platform for shaping the plant-associated community. The Plant Journal. 3: 632-645. https://doi.org/10.1111/tpj.15490
Ebert, M.K.*, Rangel, L.I.*, Spanner, R.E., Taliadoros, D., Wang, X., Friesen, T.L., de Jonge, R., Neubauer, J.D., Secor, G.A., Thomma, B.P.H.J., Stukenbrock, E.H. & M.D. Bolton. 2020. Identification and characterization of Cercospora beticola necrosis-inducing effector CbNIP1. Molecular Plant Pathology. 00:1–16. https://doi.org/10.1111/mpp.13026
Rangel, L.I., Spanner, R., Ebert, M.K., Pethybridge, S., Stukenbrock, E., de Jonge, R., Secor, G.A. & M.D. Bolton. 2020. Cercospora beticola: the intoxicating lifestyle of the leaf spot pathogen of sugar beet. Molecular Plant Pathology. 21:1020-1041. https://doi.org/10.1111/mpp.12962
Rangel, L.I., Henkels, M.D., Shaffer, B.T., Walker, F.L., Davis II, E.W., Stockwell, V.O., Bruck, D., Taylor, B.J. and J.E. Loper. 2016. Characterization of toxin complex gene clusters and insect toxicity of bacteria representing four subgroups of Pseudomonas fluorescens. PLoS One. 11(8), p.e0161120. https://doi.org/10.1371/journal.pone.0161120
Loper, J.E., Henkels, M.D., Rangel, L.I., Olcott, M.H., Walker, F.L., Bond, K.L., Kidarsa, T.A., Hesse, C.N., Sneh, B., Stockwell, V.O. and B.J. Taylor. 2016. Rhizoxin analogs, orfamide A and chitinase production contribute to the toxicity of Pseudomonas protegens strain Pf-5 to Drosophila melanogaster. Environmental Microbiology. 18(10): 3509-3521. https://doi.org/10.1111/1462-2920.13369
Henkels, M.D., Kidarsa, T.A., Shaffer, B.T, Goebel, N.C., Burlinson, P., Mavrodi, D.V., Bentley, M.A., Rangel, L.I., Davis, E.W., Thomashow, L.S., Zabriskie, T.M., Preston, G.M. and J.E. Loper. 2014. Pseudomonas protegens Pf-5 causes discoloration and pitting of mushroom caps due to the production of antifungal metabolites. Molecular Plant-Microbe Interactions. 27: 733-746. https://doi.org/10.1094/MPMI-10-13-0311-R
Loper, J.E., Hassan, K.A., Mavrodi, D.V., Davis, E.W., Lim, C.K., Shaffer, B.T., Elbourne, L.D.H., Hartney, S., Stockwell, V., Breakwell, K., Henkels, M.D., Tetu, S.G., Rangel, L.I., Wilson, N.L., vanMortel, J., Song, C., Blumhagen, R., Radune, D., Hostetler, J., Brinkac, L., Durkin, S., Kluepfel, D., Wechter, P., Anderson, A., Kim, Y.C., Pierson, L.S., Pierson, E.A., Lindow, S.E., Raaijmakers, J.M., Weller, D., Thomashow, L., Allen, A. and I.T. Paulsen. 2012. Comparative genomics of plant-associated Pseudomonas spp.: insights into diversity and inheritance of traits involved in multitrophic interactions. PLoS Genetics. 8: e1002784. https://doi.org/10.1371/journal.pgen.1002784
